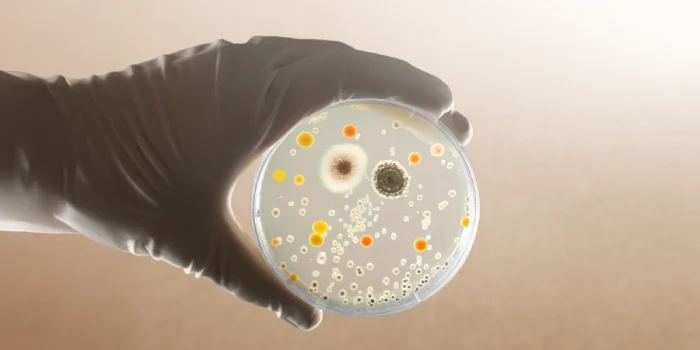
Antimicrobial Resistance Awareness

Introduction
Antibiotics once changed the course of human history—turning deadly infections into treatable conditions and saving millions of lives. Yet as bacteria continue to evolve, that medical miracle is under threat. Around the world, scientists warn that the drugs we depend on are losing their power.
This growing challenge is what Antimicrobial Resistance Awareness seeks to address. The silent spread of resistance isn’t a distant problem—it’s happening now, in hospitals, farms, and even the soil beneath our feet. Without coordinated action, routine procedures like childbirth or surgery could once again become high-risk.
The question is not whether bacteria will continue to adapt, but will we adapt fast enough to stop them?
The Hidden Battle Within
Bacteria reproduce at astonishing speed, mutating with each generation. Some of these mutations allow them to resist antibiotics designed to kill them—and those survivors multiply.
According to the WHO Global Antimicrobial Resistance and Use Surveillance System (GLASS), resistant infections now cause 1.27 million deaths annually, with millions more indirectly affected [1]. Without stronger action, resistance could claim 10 million lives every year by 2050, surpassing cancer as a global killer [2].
Hospitals are already seeing the impact. “Superbugs” such as MRSA and Klebsiella pneumoniae spread through wards, infecting surgical wounds and catheters. Meanwhile, resistant bacteria travel through trade, water, and food systems, transforming local health issues into international emergencies. The burden is especially heavy in low-resource settings, where limited access to diagnostics and clean water magnifies the crisis.
Why Bacteria Keep Winning
Bacteria are master survivors. They share resistance genes through horizontal gene transfer, form biofilms that antibiotics can’t penetrate, and lie dormant until conditions favor them again. These evolutionary tricks give them the upper hand in nearly every environment.
Every time antibiotics are misused—whether in humans or animals—bacteria gain an evolutionary advantage. In agriculture, routine antibiotic use for growth promotion fuels resistance that reaches humans through meat, produce, or soil runoff. What seems like a small overuse today can create global consequences tomorrow.
Even disinfectants and antifungals, when overapplied, can push microbes to adapt faster. Resistance is not only about medicine—it’s about every interaction between humans and the microbial world.
The One Health Connection
The One Health approach highlights how resistance moves between people, animals, and the environment.
- In healthcare, incomplete treatments and poor hygiene spread resistant infections.
- In agriculture, overuse of antibiotics in livestock promotes resistant bacteria.
- In nature, antibiotic residues from waste contaminate rivers and soil, enabling resistance genes to spread [3].
Because these systems are interconnected, controlling resistance requires collaboration between doctors, veterinarians, farmers, and environmental scientists. A single policy or sector cannot succeed alone.
How to Strengthen Antimicrobial Resistance Awareness
- Use antibiotics responsibly: Only take them when prescribed and complete every course.
- Prevent infections: Handwashing, vaccination, and hygiene reduce the need for antibiotics.
- Support sustainable farming: Choose products from producers who use antibiotics responsibly.
- Invest in innovation: New antibiotics, vaccines, and diagnostic tools are vital to stay ahead.
- Educate widely: Antimicrobial Resistance Awareness depends on public understanding and shared accountability.
Every action—no matter how small—helps slow resistance and protect future generations.
Science and Innovation in Action
Modern science is giving us new tools to fight back. Artificial intelligence can predict resistance patterns and guide treatment decisions [4]. Genetic sequencing tracks the global movement of resistant bacteria, helping health systems respond faster.
International collaborations like GLASS and the One Health Joint Plan of Action show that coordinated data, policy, and community education make measurable differences. Innovation also means exploring alternatives—bacteriophage therapy, microbiome research, and sustainable antibiotics that minimize environmental impact.
Technology helps us see what was once invisible—and awareness helps us act.
Conclusion
Antimicrobial resistance is a battle fought at the microscopic level, but its consequences are universal.
This World Antimicrobial Awareness Week, let’s make Antimicrobial Resistance Awareness more than a campaign—it’s a shared commitment to science, responsibility, and life.
By using antibiotics wisely and supporting One Health solutions, we can preserve the cures that once changed the world. Awareness is our strongest defense against evolution itself.
References
- World Health Organization (WHO), 2023. Global Antimicrobial Resistance and Use Surveillance System (GLASS) Report 2023. Geneva: WHO. Available at: https://www.who.int/initiatives/glass
- O’Neill, J., 2016. Tackling Drug-Resistant Infections Globally: Final Report and Recommendations. London: HM Government. Available at: https://amr-review.org/sites/default/files/160518_Final%20paper_
with%20cover.pdf - Bengtsson-Palme, J. and Larsson, D.G.J., 2016. Concentrations of antibiotics predicted to select for resistant bacteria: Proposed limits for environmental regulation. Environment International, 86, pp.140–149. Available at: https://pubmed.ncbi.nlm.nih.gov/26590482/
- Laxminarayan, R., Sridhar, D., Blaser, M., Wang, M. and Woolhouse, M., 2020. Achieving global targets for antimicrobial resistance. Science, 367(6475), p.eaaw9256. Available at: https://doi.org/10.1126/science.aaw9256